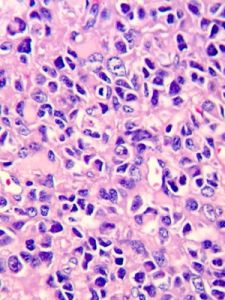
星形細胞瘤 星形細胞瘤

流行病學
圖1 星形細胞瘤據文獻報導星形細胞腫瘤占顱內腫瘤的13%~26% 占膠質瘤21.2%~51.6%,男性多於女性,男性約占60%,有報導男女之比為2∶1。
星形細胞瘤占腦腫瘤的10%~15% 多見於25~45歲的成人,平均年齡約37.5歲,無明顯性別差異, 腫瘤主要位於大腦半球,以額葉多見(46%),其次為顳葉(31%)、頂葉(15%) 位於間腦與枕葉者較少見。
間變性星形細胞瘤好發於中年,35~60歲多見,以男性稍多見,男女比為1.22∶1。病灶多發生於大腦半球,額葉居多 占40%,其次為顳葉(35%) 頂葉(17%)。少數腫瘤可見於間腦、視神經、腦幹、小腦及脊髓, 位於小腦、間腦及視神經者均少見,發生於小腦者約占小腦星形細胞腫瘤的14.4%,占顱內神經上皮源性腫瘤的0.7%~1.2%。間腦者不到顱內膠質瘤的0.5%。視神經間變性星形細胞瘤罕見。
毛細胞型星形細胞瘤占腦神經外胚葉來源腫瘤的2% 分前視路型、 下丘腦型、 小腦型、腦幹型與大腦型,以位於第三腦室附近的前視路型與下丘腦型為最多見。前視路型腫瘤累及視神經和(或)視交叉,90%發生於 20 歲以下的青少年,占顱內膠質瘤的1.7% ,其中位於眶內的前視路型腫瘤占所有眼眶腫瘤的4%。 30%~40%的神經纖維瘤病1型患者伴發前視路型腫瘤。小腦型腫瘤約占小腦膠質瘤的80%,兒童多見。而大腦型腫瘤僅占大腦半球星形細胞瘤的3%,占毛細胞型星形細胞瘤10%左右。大腦型腫瘤好發於中青年,平均年齡在 22~26 歲,以顳頂葉多見。
病因
圖2 星形細胞瘤發病機制:
星形細胞腫瘤可發生在中樞神經系統的任何部位,一般成年多見於大腦半球和丘腦 底節區,兒童多見於幕下。有報導幕上占3/4 幕下占1/4。發生在幕上者多見於額葉及顳葉,頂葉次之,枕葉較少見 腫瘤可累及兩個以上腦葉。亦可見於視神經, 丘腦和第三腦室旁;幕下者則多位於小腦半球和第四腦室,亦可見於小腦蚓部和腦幹。
1.星形細胞瘤 腫瘤主要位於白質內,呈浸潤性生長,實性者無明顯邊界,多數不限於一個腦葉,向外生長可侵及皮質 向內可破壞深部結構,亦可經過胼胝體越過中線侵犯對側大腦半球 肉眼觀察質地灰紅色或灰白色,質地多較硬,半數左右的腫瘤呈部分囊性變,囊液淡黃透明, 蛋白質含量較高,靜置易自凝,稱為Froin征陽性。有囊性變的腫瘤可稱為“囊在瘤內”。而位於小腦的星形細胞瘤常為一個大囊,囊壁上有腫瘤結節,囊壁為纖維結締組織及神經膠質纖維構成,因此只切除腫瘤結節即可達到根治腫瘤的目的, 此種腫瘤稱之為“瘤在囊內” 少數小腦星形細胞瘤為實質性,呈浸潤性生長,無明顯邊界,預後較囊性者差。
根據腫瘤的組織學特點,星形細胞瘤可分為纖維型, 原漿型和肥胖型三種亞型:
(1)纖維型:最為常見,可見於中樞神經的任何部位及各年齡組病人。在成人中多見於大腦半球;在兒童和青少年中較多見於小腦、腦幹與丘腦。生長緩慢,質地較硬韌,有時如橡皮。瀰漫型腫瘤切面呈白色,與四周腦組織不易區別。臨近皮質可被腫瘤浸潤,色澤深灰,與白質分界模糊。腫瘤中心可有囊腫形成,大小數目不定。
(2)原漿型:為最少見的一種類型, 質地軟,主要見於大腦內,多位於顳葉,部位表淺 主要侵犯大腦皮質 使受累腦回增寬、柔軟、變平為其特點, 瘤體較大,灰紅色,切面呈半透明均勻膠凍樣。深部侵入白質, 在腦內浸潤性生長,邊界不清。常有變性,形成囊腫。囊腫的大小、數目不定,周圍為瘤組織。
(3)肥胖細胞型:較少見 好發於大腦半球內,亦可見在透明隔部位,占成人大腦半球神經上皮源性腫瘤的5%~10% 占星形細胞瘤的25%。腫瘤呈浸潤性生長,生長較快,質地軟,常可見小囊形成。光鏡下見典型的肥胖細胞,體積肥大 呈球狀或多角形,胞質均勻透明,突起短而粗。瘤細胞核小,偏於一側。
2.間變性或惡性星形細胞瘤 主要見於大腦內,瘤體較大,有時侵犯幾個腦葉或者越過中線侵犯對側大腦半球。瘤組織色灰紅,質地較軟,在腦內呈浸潤性生長,與周圍腦組織有一定的邊界。腫瘤細胞可向皮質浸潤生長,形成圍繞神經元周的“衛星現象”。有囊性變和小灶性出血壞死灶。
3.毛細胞型星形細胞瘤 毛細胞型星形細胞瘤生長緩慢,來源於神經上皮組織腫瘤。腫瘤好發於中線結構的腦白質部位和小腦半球,以發生在漏斗部位者最為典型,有時稱漏斗瘤;發生於視神經稱為視神經膠質瘤, 發生於前視路、下丘腦與腦幹的腫瘤邊界欠清 ,多呈實質性, 血供豐富。
臨床表現
圖3 星形細胞瘤1.一般症狀 腫瘤的不斷生長占據顱腔內空間,腫瘤阻塞腦脊液循環通路造成腦內積水和(或)腦水腫, 腦脊液的回吸收障礙等均可造成顱內壓增高。正常顱腔容積比腦組織約大10% 當腦組織的體積增加8%~10%時尚可能無顱高壓症狀的出現,而當顱內占位病變占據150ml以上的容積時即可能產生相應的顱高壓症狀。
2.不同性質腫瘤的臨床表現
(1)星形細胞瘤:生長緩慢,病程常長達數年,平均3.5年,多數患者呈緩慢進行性發展, 癲癇常為首發症狀 50%患者以癲癇起病, 75%患者有頭痛,50%有精神運動性肌無力,出現嘔吐與明顯意識障礙分別為33%與20%。神經系統檢查多數患者有視盤水腫與腦神經障礙,均占60%。近半數患者出現肢體肌無力,而出現言語困難、感覺障礙、視野改變者也分別為20%。
(2)間變性星形細胞瘤:病程較星形細胞瘤短 平均6~24個月。大腦半球病灶主要臨床症狀為頭痛(71%)、精神症狀(51%) 肢體無力(40%)、嘔吐(29%)、言語困難(26%)、視力改變(23%)及嗜睡(22%) 癲癇發作少見。神經系統檢查可發現偏癱(59%)、視盤水腫(47%) 腦神經損害表現(46%)、偏盲(32%)、偏身感覺缺失(32%)。發病呈進行性加重,部分可出現突然惡化 間腦腫瘤早期即可有顱內壓增高表現,有偏癱、神經性無力、記憶力減退、意識混亂及癲癇與內分泌紊亂症狀。
(3)毛細胞型星形細胞瘤:一般病程較長,前視路型腫瘤位於眶內者主要表現為視力受損伴有無痛性突眼,可有不同類型的偏盲, 斜視及視神經萎縮, 腫瘤位於視交叉者則多以雙側視力受影響,有視盤水腫、 斜視、視神經萎縮及頭痛。下丘腦型腫瘤多有內分泌紊亂、間腦綜合徵、Frölich綜合徵與早熟。直徑2cm以上的腫瘤可引起腦積水。
症狀
一。腫瘤的不斷生長占據顱腔內空間,腫瘤阻塞腦脊液循環通路造成腦內積水和(或)腦水腫,腦脊液的回吸收障礙等均可造成顱內壓增高。
二。正常顱腔容積比腦組織約大10%,當腦組織的體積增加8%~10%時尚可能無顱高壓症狀的出現,而當顱內占位病變占據150ml以上的容積時即可能產生相應的顱高壓症狀。
三。大腦半球的星形細胞瘤發病緩慢,病程較長,多數先出現由於腫瘤直接破壞所造成的定位體徵和症狀,隨後又出現顱內壓增高的症狀。
四。小腦星形細胞瘤由於較早的影響腦脊液循環通路,多先出現顱內壓增高症狀,腦幹的星形細胞瘤進展較快,病程較短,早期出現腦神經損害和錐體束征,而顱內壓增高的症狀常見於晚期。
五。顱內壓增高的症狀主要包括頭疼、嘔吐、視盤水腫,視力視野改變,癲癇、復視,頭顱擴大(兒童期)和生命體徵的改變等。
併發症
如進行手術治療,可能發生以下併發症:
1.顱內出血或血腫 與術中止血不仔細有關,隨著手術技巧的提高,此併發症已較少發生。創面仔細止血,關顱前反覆沖洗,即可減少或避免術後顱內出血。
2.腦水腫及術後高顱壓 可用脫水藥物降低顱內壓,糖皮質激素減輕腦水腫。
3.神經功能缺失 與術中損傷重要功能區及重要結構有關,術中儘可能避免損傷 出現後對症處理。
診斷
圖6 星形細胞瘤鑑別診斷:
星形細胞瘤與腦梗死急性期和脫髓鞘性疾病的急性期難以鑑別,只有加強隨訪才能進行區別。急性腦梗死和脫髓鞘疾病分別在5~10天及3~6周后,頭顱CT與MRI上會出現病變的典型變化,而星形細胞瘤短期內在影像學上將不會發生變化。下丘腦毛細胞型星形細胞瘤MRI檢查由於腫瘤信號均勻,可明顯增強, 常不易與實質性顱咽管瘤及鞍上生殖細胞瘤等鑑別。
實驗室檢查:
腰椎穿刺對已有明顯顱內壓增高患者應視為禁忌。一般星形細胞瘤多表現不同程度的顱內壓增高,腦脊液檢查白細胞多數正常而蛋白含量增高, 這在腫瘤接近腦室或蛛網膜下腔時尤為明顯,但腦脊液蛋白含量正常也不能排除腫瘤的存在。
其它輔助檢查:
1.神經電生理學檢查 腦電圖對以癲癇為首發症狀者有一定的幫助,主要表現為局灶性低幅慢波, 部分表現為廣泛的中度或重度異常,視覺誘發電位(VEP)檢查對視神經膠質瘤, 顳枕葉腫瘤有幫助, 腦幹聽覺誘發電位(BAEP)則有助於腦幹, 小腦等部位腫瘤的診斷。
2.X線檢查 多數患者頭顱X線平片表現顱內壓增高。部分可見到點狀或圓弧狀鈣化,視神經腫瘤可見視神經孔的擴大並可導致前床突及鞍結節變形而形成“梨形蝶鞍”。腦血管造影可見血管受壓移位,少見腫瘤染色和病理血管 腦室造影幕上腫瘤可見腦室的移位和充盈缺損;小腦腫瘤表現為第三腦室以上的對稱擴張,導水管下段前屈,第四腦室受壓及向對側移位。
3.CT檢查 纖維型和原漿型星形細胞瘤,因組織含水量達81%~82%,CT多呈低密度,較均勻一致,占位效應不明顯 瘤內無出血灶或壞死灶,瘤周無明顯水腫影。除少數病例外,一般注射造影劑不增強或稍有增強。因腫瘤所在的部位和大小而異,表現相應的占位效應。小腦星形細胞瘤在CT上腫瘤的實質部分呈低(或)混雜密度病灶,造影劑增強後可有輕度增強,而囊腔部分則始終保持低密度影。囊壁部分可呈環形或弧線形增強。腦幹部位的星形細胞瘤CT上可見腦幹的增粗,左右不對稱及出現低密度或混雜密度的腫瘤病灶影, CT顯示腦幹膠質瘤不如MRI理想。部分腫瘤CT上呈等密度,從而使腫瘤在CT上難以發現,此時MRI可明確顯示腫瘤影(圖1)。
間變性星形細胞瘤CT上呈低密度或不均一低密度與高密度混雜病灶(圖2) 90%腫瘤占位效應明顯,伴有瘤周水腫,20%有囊變,10%可見鈣化。
4.MRI檢查 星形細胞瘤在MRI上T1W呈低信號 T2W呈高信號。MRI可清楚顯示腫瘤浸潤腦組織的程度。增強後星形細胞瘤一般不強化, 少數腫瘤有周邊斑點狀輕度強化影。良性星形細胞瘤由於腫瘤的生長,使腫瘤內外水分增多,造成T1和T2延長 表現T1加權像呈低信號,T2加權像呈高信號(圖3),信號強度均勻,瘤周水腫輕微,注射Gd-DTPA增強不明顯。隨著腫瘤的生長,瘤內發生囊變使得MRI不均勻,瘤體和周圍水腫在T1加權像上不如T2加權像上容易區分,腫瘤可有輕度的增強, 惡性星形細胞瘤在T1加權相上呈混雜信號 以低信號為主,間以更低信號或高信號,體現了腫瘤內壞死或出血。
間變性星形細胞瘤在MRI上,腫瘤T1W為低信號 T2W為高信號,較多形性膠母細胞瘤影像稍均勻, 無壞死或出血灶。增強後,80%~90%腫瘤有強化(圖6)。腫瘤強化表現不一,可為環形 結節形、不規則形等,另有部分腫瘤強化均勻一致。
治療及預後
星形細胞瘤的治療方案尚存在爭論, 由於腫瘤生長緩慢, 在患者出現症狀前後的影像學上可長期無明顯改變,因此有作者認為對星形細胞瘤治療的目的是以改善患者神經系統症狀為主,對長期無症狀的患者可對其進行間隔期為3個月的影像學檢查隨訪。更有作者提出放療或是手術可加重症狀,並且有時非但不能減緩腫瘤惡變的發生,甚至有促使腫瘤惡變的可能。
當患者出現明顯的神經系統症狀或影像學檢查發現腫瘤明顯增大,應積極治療。治療以手術為主, 爭取做到腫瘤全切除。腫瘤範圍切除愈廣,對放療效果愈佳,且可減少易引起惡變的腫瘤細胞。腫瘤經常自皮質表面一直長向深部白質。在皮質處腫瘤常有清楚界限,而深部白質u纖維處腫瘤與正常組織界限不清。
毛細胞型星形細胞瘤生長速度極慢,部分作者認為腫瘤可長期靜止,有的甚至可自然退縮,治療以手術為主。手術切除的程度和預後直接相關, 對於毛細胞星形細胞瘤,應當爭取手術全切除,這是提高療效、減少復發的根本措施, 對於未能全切除者可給予一定劑量的放療, 不主張化學治療。對前視路型腫瘤,由於手術或放療可直接或間接地影響視力,導致失明, 因此曾提出多種治療方案 如:單純放療;病灶活檢後行放療;病灶活檢後僅對視交叉後方生長的腫瘤行放療;病灶活檢後對單側視神經腫瘤行切除;對單側視神經腫瘤行切除,其餘病灶放療。
預後:
星形細胞瘤經手術和(或)放療後,預後尚佳, 認為腫瘤的病理類型、手術切除程度、發病年齡、病程、臨床表現均可反應患者的預後。肥大細胞型星形細胞瘤患者預後較差,而病程長、年齡輕、腫瘤位於小腦、以癲癇為主要表現、無頭痛及性格改變、腫瘤全切除者, 一般預後較佳。腫瘤全切者5年生存率可達80%,而部分切除腫瘤或行腫瘤活檢者5年生存率僅為45%~50% 對40歲以上腫瘤次全切除的患者,放療可獲得滿意效果。腫瘤復發預後不佳,約半數腫瘤復發後惡變,近1/3腫瘤復發後演變為膠母細胞瘤。復發後腫瘤的快速生長常為死亡原因。